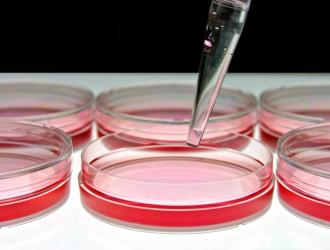

Comunemente nota come “ameba mangia-cervello”, Naegleria fowleri ha riconquistato gli onori delle cronache dopo che l’estate scorsa un bambino del Nebraska è morto di amebasi, un’infezione dell’acqua.
Naegleria fowleri si sviluppa al meglio in acqua dolce e calda, il che la...